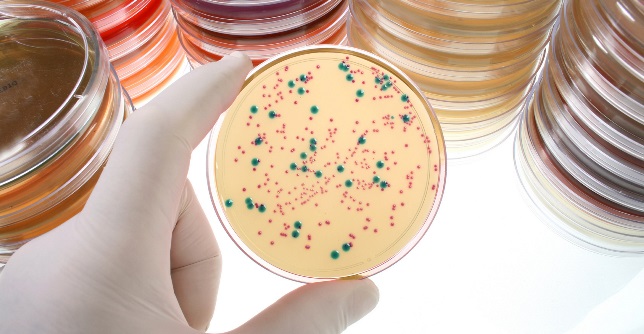

El carácter autóctono de los vinos, también en las levaduras
La empresa biotecnológica Guserbiot ha desarrollado 2 levaduras autóctonas de Rioja y Rioja Alavesa para la elaboración de vino tinto
Carmen Fernández
Martes 30 de Julio de 2013
Leído › 9604 veces
En lugar de utilizar una levadura genérica para asegurar el correcto desarrollo de la fermentación alcohólica, esta vendimia, las bodegas tendrán la oportunidad de elaborar sus caldos con levaduras autóctonas, aisladas y seleccionadas por la empresa biotecnológica Guserbiot.
Es un producto pionero a nivel nacional, que busca reforzar la identidad y autenticidad de los caldos de Rioja y Rioja Alavesa. El proyecto, iniciado en 2004, ha contado con la colaboración de las bodegas de Marqués de Riscal y Baigorri que mediante catas han testado y validado el producto en las distintas añadas en las que se ha aplicado, así como de la Fundación LEIA, y está listo para su comercialización de cara a la vendimia de este año.
Los vinos de Rioja y Rioja Alavesa ya tenían la autoestima bien alta; ya habían logrado un reconocimiento y un prestigio internacional que les permitía competir en un mercado global cada vez más complicado tras muchas décadas de apuesta decidida por la innovación de los sistemas de producción y elaboración. Ahora, además, podrán presumir de ser auténticos, diferentes, 100% Autóctonos.
Si la tierra, el aire, la uva y el sol son de aquí, ¿por qué incorporar a nuestros vinos algo producido a miles de kilómetros de aquí?
Las levaduras premium de Guserbiot garantizan el origen del único ingrediente capaz de hacer los vinos aún más especiales. ¿De dónde proceden las levaduras genéricas? ¿Dónde están aisladas?. Con las Levaduras autóctonas de Guserbiot todas estas preguntas tienen respuesta.

En primer lugar, se encuentra la levadura autóctona aislada en la Rioja Alavesa y seleccionada por Guserbiot, a partir de uvas de la variedad Tempranillo. Idónea para la elaboración de vinos tintos. Su uso ofrece unas ventajas únicas, permitiéndote un mayor control sobre la fermentación, realzando las propiedades especificas de cada vino y potenciando sus cualidades sensoriales, favoreciendo la expresión de notas florales y frutales.
Ficha técnica de la Levadura Autóctona Rioja Alavesa

En segundo lugar, se encuentra la levadura autóctona aislada en la Comunidad de La Rioja perteneciente a la especie Saccharomyces cerevisiae, y seleccionada por Guserbiot, a partir de uva Tempranillo. Idónea para la elaboración de vinos tintos tanto por despalillado como por maceración carbónica. Su uso ofrece unas ventajas únicas, permitiéndote un mayor control sobre la fermentación, realzando los sabores y aromas varietales y otorgando a tus vinos un equilibrio y calidad con muy buena acidez y volumen en boca.
Ficha técnica de la Levadura Autóctona Rioja
Esta gama de levaduras, además de agotar los azúcares, proporcionan una cinética rápida y regular, poseen una gran capacidad fermentativa y una elevada producción de glicerol. Las Levaduras Premium de Guserbiot aportan un valor añadido a las bodegas, al tratarse de levaduras "no genéricas", aisladas y seleccionadas para la elaboración de diferentes caldos. Levaduras que realzan los sabores y aromas varietales, favoreciendo la expresión de notas frutales, y proporcionando equilibrio y calidad del vino, con muy buena acidez y volumen en boca.
Origen
Las levaduras del género Saccharomyces, son las responsables de la transformación del mosto mediante un proceso denominado fermentación alcohólica, que permite convertir un medio rico en azúcares en un medio cuyo principal componente es etanol. Durante la fermentación alcohólica, Saccharomyces cerevisiae produce numerosos aromas y sabores, siendo este proceso el responsable de que el producto final tenga un complejo perfil organoléptico. Además de la influencia en el aroma y sabor, las levaduras también tienen cierta influencia en el color del vino.
Ya en 1876 Pasteur afirmaba que, "las cualidades del vino dependen en gran parte de la naturaleza específica de las levaduras que se desarrollan durante la fermentación de los mostos. Podemos pensar que si se sometiese un mismo mosto a la acción de levaduras distintas se lograrían vinos de distinta naturaleza".
Desde un punto de vista microbiológico, las fermentaciones espontáneas, aunque naturales, son difíciles de controlar, ya que el mosto no es estéril, por lo que el proceso fermentativo puede verse afectado por la concentración y calidad de las cepas presentes, pudiendo resultar en desviaciones de la calidad organoléptica final del vino. Esta falta de control microbiológico y por lo tanto el riesgo de obtener un producto desviado, se subsanan con el uso de levaduras seleccionadas.
Desde hace más de 20 años, la práctica totalidad de los productores de vino de las diferentes denominaciones de origen recurren a levaduras externas comerciales, importadas de países como Francia o Australia, para incorporarlas al proceso de elaboración del vino, ya que, como afirma el Presidente de Guserbiot, Sergio Gutiérrez, "nadie se arriesga hoy en día a fermentar un vino de un cierto valor sin asegurarse que la fermentación espontánea no se va a paralizar". Pero la pregunta es; si la tierra, el aire, la uva y el sol son de aquí, ¿por qué incorporar a nuestros vinos algo producido a miles de kilómetros de aquí?. Guserbiot te da la oportunidad de hacer tus vinos 100% autóctonos.
| Más información |
|---|
| (PDF)Catálogo de Levaduras Premium |
| Francis Barbero, Directora de I+D+i de Guserbiot: “Las levaduras son el punto de |
Licenciada en CC de la Información y especializada en enogastronomía y turismo
Leído › 9604 veces